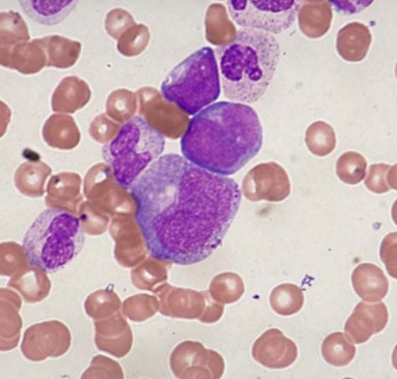

백혈병 초기 증상 · 자가 체크 · 체중 감소· 피로감

백혈병은 혈액 세포에 발생하는 암으로 조기 발견이 매우 중요합니다. 하지만 초기 증상은 감기나 피로감처럼 일상적인 질환과 유사해 쉽게 지나칠 수 있습니다. 이번 글에서는 백혈병의 초기 증상을 구체적으로 살펴보고, 의심해야 할 신호에 대해 알아봅니다.
1. 백혈병이란?
백혈병은 골수에서 비정상적인 백혈구가 과다 생성되는 질환입니다. 백혈구는 원래 외부 병원체로부터 몸을 지키는 역할을 하지만, 백혈병에서는 기능을 제대로 하지 못하는 세포가 늘어나 면역력 저하, 출혈, 빈혈, 감염 등의 문제가 발생합니다.
백혈병은 급성과 만성으로 나뉘며, 나이에 따라 소아백혈병과 성인백혈병으로도 구분됩니다.


백혈병 초기 증상 1 – 이유 없는 피로감과 무기력
가장 흔하면서도 자주 간과되는 증상은 극심한 피로감입니다. 평소보다 쉽게 지치고, 충분히 잠을 자도 개운하지 않은 경우 주의가 필요합니다. 백혈병은 정상적인 적혈구 생성을 방해하여 산소 공급이 줄어들고, 만성적인 무기력 상태로 이어집니다.

백혈병 초기 증상 2 – 반복되는 감기와 잦은 감염
면역력을 담당하는 백혈구에 문제가 생기면, 작은 감염에도 쉽게 아프고 회복이 더딜 수 있습니다.
- 잦은 감기
- 입안 염증
- 잇몸 감염
- 피부 곪음 등
반복적인 감염이 지속된다면 백혈병을 의심해볼 필요가 있습니다.
백혈병 초기 증상 3 – 멍과 출혈
별다른 외상이 없는데도 쉽게 멍이 들거나 코피, 잇몸 출혈이 자주 발생한다면 혈소판 수치가 낮아졌을 가능성이 있습니다. 백혈병은 혈소판 생성도 억제하기 때문에 **지혈 능력에 문제가 생기고, 점상출혈(작은 붉은 반점)**이 피부에 생기기도 합니다.
백혈병 초기 증상 4 – 체중 감소 및 식욕 저하
특별히 식이 조절을 하지 않았는데도 갑자기 살이 빠지거나 식욕이 뚝 떨어지는 경우, 체내 대사 변화와 백혈병 세포의 증가로 인한 소화기계 부담 때문일 수 있습니다.
- 설명할 수 없는 체중 감소
- 음식 섭취가 부담스럽고 소화가 안 되는 느낌
이러한 증상이 병행된다면 단순한 위장 질환이 아닐 수도 있습니다.
백혈병 초기 증상 5 – 야간 발한과 고열, 오한
밤에 땀이 많이 나는 증상은 일부 암에서 나타나는 전형적인 징후입니다. 백혈병 환자들도 밤에 이불이 젖을 정도로 땀을 흘리거나, 이유 없이 고열과 오한을 반복하는 경우가 많습니다. 일반 감기와 달리 해열제를 먹어도 열이 잘 내려가지 않거나 계속 재발하면, 빠르게 병원을 찾아야 합니다.
2. 백혈병을 의심해야 할 때
아래 항목에 3가지 이상 해당된다면, 혈액검사 및 전문의 상담을 권장합니다:
- 쉽게 피곤하고 아침에도 개운하지 않다
- 이유 없이 살이 빠졌다
- 입안이나 피부에 염증이 자주 생긴다
- 출혈이 쉽게 멎지 않는다
- 밤에 땀이 심하고 열이 반복된다
3. 백혈병은 조기 발견이 중요합니다
백혈병은 조기에 발견하고 치료를 시작하면 완치 가능성도 높습니다. 특히 성인 급성 백혈병의 경우 초기 대응 속도에 따라 예후가 달라질 수 있기 때문에, 초기 증상에 대한 인식과 대처가 무엇보다 중요합니다.
조금이라도 이상하다고 느껴지면 스스로 넘기지 말고, 가까운 내과나 혈액종양내과에서 혈액검사를 받아보는 것이 가장 확실한 방법입니다.


✅ 마무리 TIP
- 백혈병 초기 증상은 감기, 스트레스성 피로와 혼동되기 쉬우므로 주의 깊게 살펴야 합니다.
- 건강검진 시 정기적으로 혈액 수치를 확인하는 습관을 들이세요.
- 증상에 대한 정보를 널리 공유하는 것도 큰 도움이 됩니다.
'여성, 건강' 카테고리의 다른 글
| 비인두암 예방방법, 생활습관 교정 (1) | 2025.11.23 |
|---|---|
| 비인두암 증상·원인·치료방법·생존율 완전정리 (0) | 2025.11.23 |
| 송화가루 알레르기 대처법 : 봄철 알레르기 증상 줄이는 방법 (2) | 2025.04.29 |
| 서울 홍역 예방 접종 가능한 병원 (0) | 2025.03.24 |
| 성인도 홍역 예방 접종이 필요할까? 홍역 핵심 정보 (0) | 2025.03.24 |